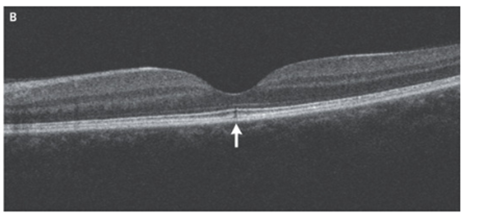

- 2025年9月30日
- 2025年12月22日
太陽網膜症(太陽を直視してはいけない理由)
43歳男性。特記すべき既往なし。
約3週間前から目のかすみ症状を認め、眼科受診。
眼の痛みや暗点は認めなかった。
眼を保護せずに夕日を眺める習慣が何年にもわたりあったとのことであった。
視力は右眼 0.67、左眼0.4であった。
眼底検査では正常であった。

細隙灯検査も正常であった。
左黄斑の光干渉断層撮影法(OCT)施行。中心窩の光受容体の内側と外側の部分および網膜色素上皮の咬合帯の不連続性を認めた(矢印部位)。
右のOCTは正常だった。
「太陽網膜症」と診断。
太陽網膜症は紫外線によって引き起こされる網膜の光化学障害。
原因には日食の観察、アーク溶接機やレーザーポインターへの暴露、太陽の直接観察がある。
視力は数か月かけて回復する可能性もあるが、変視症(形状の誤認)や中心暗点が永遠に残る場合もある。
太陽を直接見つめないようにするアドバイスがなされた。
残念ながら患者はフォローアップに現れなかった。
N Engl J Med 2023; 389:165
DOI: 10.1056/NEJMicm2215436
柏五味歯科内科リウマチクリニック
ホームページ